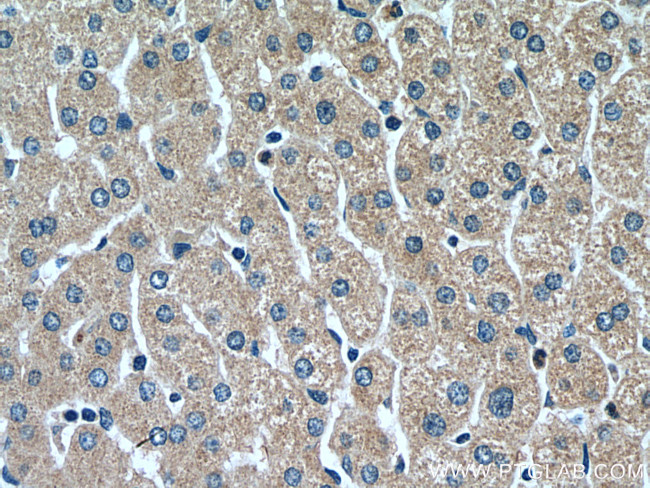
RETN Antibody in Immunohistochemistry (Paraffin) (IHC (P))

Search
Proteintech
RETN Polyclonal Antibody
{{$productOrderCtrl.translations['antibody.pdp.commerceCard.promotion.promotions']}}
{{$productOrderCtrl.translations['antibody.pdp.commerceCard.promotion.viewpromo']}}
{{$productOrderCtrl.translations['antibody.pdp.commerceCard.promotion.promocode']}}: {{promo.promoCode}} {{promo.promoTitle}} {{promo.promoDescription}}. {{$productOrderCtrl.translations['antibody.pdp.commerceCard.promotion.learnmore']}}
产品信息
18170-1-AP
种属反应
宿主/亚型
分类
类型
抗原
偶联物
形式
浓度
规格
纯化类型
保存液
内含物
保存条件
运输条件
产品详细信息
Aliquoting is unnecessary for -20°C storage.
靶标信息
Adipose tissue is an energy reserve in animals and is strictly regulated. Adipose cells produce and secrete numerous physiologically important proteins, such as lipoprotein lipase (LPL), leptin, adipocyte complement related protein of 30 kDa (Acrp30), perilipin, and resistin. Resistin, also known as Adipocyte Secreted Factor (ADSF) and FIZZ3, is a cytokine that is specifically secreted by adipocytes. While the function of resistin is not well understood, it appears to have key paracrine roles and has a suggested role in type 2 diabetes. Studies show that in obese, diabetic mice the levels of serum resistin are increased, which has an antagonistic effect on insulin. Additional studies have shown that resistin causes insulin resistance and glucose intolerance in mice. Resistin gene expression requires C/EBP alpha, which is necessary and sufficient for expression. Studies show that the coactivators CBP and p300, which have been shown to display histone acetyltransferase (HAT) activity, abundantly acetylate the histones at the resistin promoter suggesting their role in activating chromatin for resistin transcription. Numerous PPAR gamma and RXR ligands have been shown to downregulate resistin expression in adipocytes.
仅用于科研。不用于诊断过程。未经明确授权不得转售。
生物信息学
蛋白别名: A12-2; Adipose tissue specific secretory factor; Adipose tissue-specific secretory factor; ADSF; C/EBP epsilon regulated myeloid specific secreted cysteine rich protein precursor 1; C/EBP-epsilon regulated myeloid-specific secreted cysteine-rich protein precursor 1; C/EBP-epsilon-regulated myeloid-specific secreted cysteine-rich protein; cysteine-r; Cysteine-rich secreted protein A12-alpha-like 2; Cysteine-rich secreted protein FIZZ3; dri; found in inflammatory zone 3; MGC126603; MGC126609; Resistin; resistin delta2; RSN
基因别名: ADSF; FIZZ3; HXCP1; RENT; RETN; RETN1; RSTN; UNQ407/PRO1199; XCP1
UniProt ID: (Human) Q9HD89
Entrez Gene ID: (Human) 56729